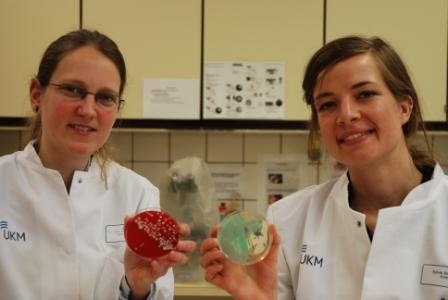
Annelene Kossow (l.) und Sylvia Schaber haben an der Hygiene-Akademie in...

Krankenhaushygiene: Neue Akademie bildet dringend benötigte Fachärzte aus
Das Universitätsklinikum Münster (UKM) und die Medizinische Fakultät Münster verstärken die Ausbildung von dringend benötigten Fachärzten für Hygiene und Umweltmedizin für die Krankenhaushygiene in Deutschland.
Am Institut für Hygiene in Münster wurde jetzt mit der „Westfälischen Akademie für Krankenhaushygiene" das erste strukturierte Weiterbildungszentrum dieser Art für angehende Fachärzte auf diesem Gebiet in Deutschland gegründet. „Damit wollen wir gezielt den Nachwuchs in den Bereichen der Hygiene und Umweltmedizin ausbilden und fördern sowie grundlagenwissenschaftliche Erkenntnisse aus der Forschung in die Präventionsmaßnahmen integrieren.
Denn nur wenn die Infektions- und Übertragungswege von Krankheitserregern weiter erforscht und die Gefahrenquellen exakt aufgedeckt werden, können wir noch effektivere Gegenmaßnahmen ergreifen. Und dazu brauchen wir Experten", beschreibt Institutsdirektor Prof. Dr. Dr. h.c. Helge Karch die Ziele des neuen Angebots.
Aktuell absolvieren mit Annelene Kossow, Sylvia Schaber und Dr. Robin Köck in Münster drei junge Mediziner die fünfjährige Weiterbildung zum Facharzt für Hygiene und Umweltmedizin. Zukünftig soll die Westfälische Akademie für Krankenhaushygiene auch Ärzten anderer Kliniken offenstehen, um in Kooperation die Facharztausbildung in Münster zu absolvieren.
„Im Anschluss an die Ausbildung können die Kolleginnen und Kollegen dann als Facharzt für Hygiene an Krankenhäusern eigenständig arbeiten", erklärt PD Dr. Dr. Frank Kipp, Leitender Krankenhaushygieniker am Universitätsklinikum Münster (UKM).
Dr. Kipp übernimmt gemeinsam mit PD Dr. Alexander Mellmann die ärztliche Leitung der Akademie. Er weist auf den aktuellen Fachkräftemangel in Deutschland hin: „Durch die neue Gesetzgebung benötigt jede Klinik mit mehr als 400 Betten einen eigenen hauptamtlichen Krankenhaushygieniker. Dem Bedarf von mindestens 400 fachärztlichen Krankenhaushygienikern stehen aktuell allerdings nur knapp 70 Fachärzte für Hygiene entgegen, die tatsächlich in der Krankenhausversorgung tätig sind, davon alleine drei am Universitätsklinikum Münster. Wir sehen es auch als unsere Pflicht, diesem Mangel durch gezielte Weiterbildung entgegenzuwirken."
Am klinischen Alltag orientierte Forschung
Ebenso wichtig sei allerdings die am klinischen Alltag orientierte Forschung, die die zweite Säule der Hygiene-Akademie in Münster darstellt. Schon während der Weiterbildungsphase werden die Teilnehmer frühzeitig in praxisorientierte Forschungsprojekte des Institutes für Hygiene eingebunden.
„Die exakte Typisierung von Krankheitserregern ist ein Beispiel für ein derartiges Forschungsprojekt, dessen Ergebnisse der Umsetzung rationaler Hygienemaßnahmen direkt am Patienten dienen. Aber auch die Besiedlungsmechanismen, z.B. von MRSA, stehen hierbei im Mittelpunkt", erklärt Dr. Alexander Mellmann. Ziel ist es, neues Grundlagenwissen in die Prävention von Krankenhausinfektionen zu überführen.
Prof. Dr. Norbert Roeder, Ärztlicher Direktor und Vorstandsvorsitzender des UKM: „Bereits seit mehr als fünf Jahren wird am UKM jeder stationär aufgenommene Patient auf eine MRSA-Besiedelung gestestet. Durch dieses Screening und die bestehenden Hygienestandards konnten wir die Krankenhausinfektionen enorm reduzieren. Davon profitieren natürlich in erster Linie die Patienten, aber auch wir als Klinik: Denn die hohe Folgekosten bei einer Infektion, etwa durch Isolierung der Patienten oder durch den erhöhten Arbeitsaufwand, können deutlich reduziert werden."
An der Medizinischen Fakultät Münster nimmt das Thema Krankenhaushygiene schon im Studium breiten Raum ein: „In unserem Studienhospital lernen die Studierenden in authentischer Stationsumgebung praktisch, wie wichtig z.B. die Händedesinfektion ist. Dort wird in speziellen Hygiene-Kursen gezeigt, welche Übertragungswege es gibt und wie diese Wege durch geeignete Hygienemaßnahmen unterbrochen werden können und müssen. Denn Hygiene muss alltäglicher Bestandteil der ärztlichen Tätigkeit sein und darf keineswegs als zusätzliche Arbeit empfunden werden", erklärt Prof. Dr. Wilhelm Schmitz, Dekan der Medizinischen Fakultät. So sollen angehende Mediziner bereits frühzeitig sensibilisiert und für die Fachrichtung Hygiene interessiert werden.
Prof. Karch: „Krankenhaushygiene ist direkte Infektionsprävention und dient unmittelbar der Patientensicherheit. Diese Sichtweise muss sich noch viel stärker durchsetzen. Auch daran müssen wir arbeiten. Denn wenn z.B. ein Chirurg eine schwierige Operation erfolgreich meistert, wird dies natürlich völlig zurecht von den Patienten und seinen Angehörigen registriert. Wenn ein Krankenhaushygieniker erfolgreich Infektionen verhindert und so Leben rettet, bekommt dies niemand mit. Umso mehr freue ich mich, dass wir unsere Akademie jetzt mit drei jungen, wissenschaftlich engagierten Ärzten starten konnten, die sich für unsere Fachdisziplin entschieden haben und neben dem Facharzt für Hygiene und Umweltmedizin auch die Hochschullehrerlaufbahn anstreben."
Hintergrund: „Institut für Hygiene" Münster
Das Institut für Hygiene am Universitätsklinikum Münster ist eines der wenigen eigenständigen Institute für Hygiene und Umweltmedizin in Deutschland. Es bietet die gesamte Bandbreite der in der Weiterbildungsordnung geforderten Inhalte im Gebiet der Hygiene und Umweltmedizin.
Das Institut bildet in Kooperation mit der Ärztekammer Westfalen Lippe bereits seit Jahren Hygienebeauftragte Ärzte aus. Weiterhin werden am Institut in enger Zusammenarbeit mit der Johanniterakademie Münster Hygienefachpflegekräfte ausgebildet, so dass neben der Facharztweiterbildung alle zurzeit in Deutschland vorhandenen curriculären Weiterbildungsmöglichkeiten in der Hygiene und Umweltmedizin angeboten werden. Das Institut ist eines von derzeit fünf von der Deutschen Gesellschaft für Hygiene und Mikrobiologie (DGHM) anerkannten Fortbildungsstätten für Krankenhaushygiene.















